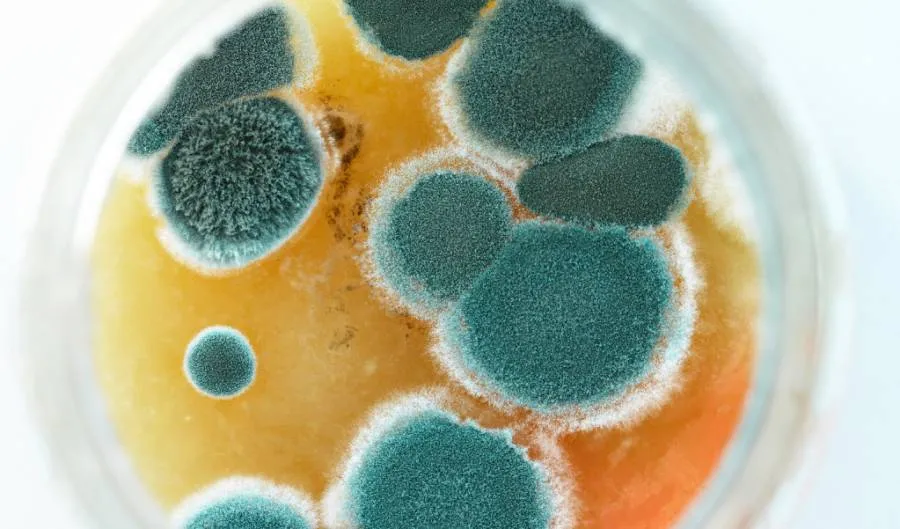
Moho Trichoderma

· Felipe Vengoechea · acerca-de-hongos
Descubriendo el Mundo Invisible de los Hongos Microscópicos: Una Guía Completa
Desde la levadura que fermenta tu pan hasta el moho que nos dio la penicilina. Explora la biología, importancia y diversidad de los hongos microscópicos.

Definición y Características de los Hongos Microscópicos
Los hongos microscópicos son un grupo de organismos que, como su nombre indica, son tan pequeños que necesitan un microscopio para ser vistos. Son parte del reino Fungi, que también incluye organismos más grandes y visibles como los hongos y las setas. Los hongos microscópicos son increíblemente diversos, con miles de especies identificadas hasta la fecha. Aunque son pequeños, juegan un papel crucial en los ecosistemas de todo el mundo, descomponiendo la materia orgánica y reciclando nutrientes.

Los hongos microscópicos tienen una variedad de formas y tamaños. Algunos son unicelulares, como las levaduras, mientras que otros forman redes complejas de filamentos llamadas micelios. A pesar de su diversidad, todos los hongos microscópicos comparten algunas características comunes. Todos son eucariotas, lo que significa que tienen células con núcleos y orgánulos. También tienen paredes celulares hechas de quitina, un material resistente que también se encuentra en los exoesqueletos de los insectos.
Importancia de los Hongos Microscópicos en la Naturaleza
Los hongos microscópicos son vitales para el funcionamiento de los ecosistemas terrestres. Desempeñan un papel clave en la descomposición de la materia orgánica, liberando nutrientes que pueden ser utilizados por otras plantas y animales. Sin los hongos microscópicos, las hojas caídas, los troncos muertos y otros desechos orgánicos se acumularían, y los nutrientes quedarían atrapados en estas formas de materia inutilizables.
Además de su papel en la descomposición, los hongos microscópicos también forman relaciones simbióticas con las plantas. Muchas plantas dependen de los hongos microscópicos para ayudarles a absorber agua y nutrientes del suelo. A cambio, las plantas proporcionan a los hongos azúcares y otros nutrientes que producen a través de la fotosíntesis. Esta relación simbiótica, conocida como micorriza, es esencial para la salud y el crecimiento de muchas plantas.
Tipos de Hongos Microscópicos
Hongos Filamentosos: Aspergillus, Penicillium y Fusarium
Los hongos filamentosos son un tipo de hongo microscópico que se caracteriza por su crecimiento en forma de filamentos o hifas. Estos filamentos pueden entrelazarse para formar una red compleja conocida como micelio. Algunos de los hongos filamentosos más conocidos incluyen los géneros Aspergillus, Penicillium y Fusarium.
Aspergillus es un género de hongos que se encuentra comúnmente en el suelo y en ambientes interiores. Algunas especies de Aspergillus son útiles para los humanos, como Aspergillus oryzae, que se utiliza en la fermentación de alimentos como el sake y la salsa de soja. Sin embargo, otras especies pueden ser perjudiciales, como Aspergillus fumigatus, que puede causar infecciones pulmonares en personas con sistemas inmunológicos debilitados.

Penicillium es otro género de hongos filamentosos, famoso por ser el género del que se descubrió la penicilina, el primer antibiótico. Penicillium chrysogenum, la especie de la que se aisló la penicilina, se encuentra comúnmente en el aire y en el suelo. Otros miembros del género Penicillium se utilizan en la producción de quesos como el Roquefort y el Camembert.

Fusarium es un género de hongos filamentosos que se encuentra en el suelo y en las plantas. Algunas especies de Fusarium son patógenos de las plantas, causando enfermedades como la marchitez del fusarium en los tomates y el tizón del fusarium en los plátanos. Sin embargo, otras especies de Fusarium se utilizan en la producción de alimentos fermentados, como el tempeh.
Levaduras: Saccharomyces, Candida y Cryptococcus
Las levaduras son hongos microscópicos unicelulares que se reproducen por gemación, un proceso en el que una célula madre produce una célula hija que luego se separa. Las levaduras son importantes tanto en la naturaleza como en la industria. Descomponen los azúcares y producen alcohol y dióxido de carbono, un proceso que se utiliza en la fabricación de pan, cerveza y vino.

Saccharomyces es un género de levaduras que incluye a Saccharomyces cerevisiae, la levadura de panadería y cervecería. S. cerevisiae ha sido utilizada por los humanos durante miles de años para fermentar alimentos y bebidas. También es un organismo modelo en la investigación biológica, y ha proporcionado importantes conocimientos sobre la biología celular y molecular.
Candida es otro género de levaduras, algunas de las cuales pueden causar infecciones en los humanos. Candida albicans, por ejemplo, es una parte normal de la flora del cuerpo humano, pero puede causar infecciones oportunistas en personas con sistemas inmunológicos debilitados. Estas infecciones pueden variar desde la candidiasis oral y vaginal hasta infecciones sistémicas potencialmente mortales.
Cryptococcus es un género de levaduras que incluye a Cryptococcus neoformans, un patógeno humano importante. C. neoformans puede causar meningitis criptocócica, una infección grave del cerebro y la médula espinal, en personas con sistemas inmunológicos debilitados, como los pacientes con SIDA.
Hongos Dimórficos: Histoplasma y Coccidioides
Los hongos dimórficos son hongos microscópicos que pueden cambiar entre dos formas diferentes dependiendo de las condiciones ambientales. Por ejemplo, pueden crecer como levaduras a temperaturas corporales y como moldes a temperaturas más bajas. Este dimorfismo es una adaptación que permite a estos hongos sobrevivir y proliferar en una variedad de ambientes.
Histoplasma es un género de hongos dimórficos que incluye a Histoplasma capsulatum, el agente causante de la histoplasmosis. H. capsulatum vive en el suelo y en las heces de aves y murciélagos, y puede ser inhalado por los humanos cuando se remueve el suelo o las heces. Una vez en los pulmones, el hongo puede causar una infección que varía desde una enfermedad leve similar a la gripe hasta una enfermedad pulmonar grave.
Coccidioides es otro género de hongos dimórficos que incluye a Coccidioides immitis y Coccidioides posadasii, los agentes causantes de la coccidioidomicosis, o fiebre del valle. Estos hongos se encuentran en el suelo de ciertas áreas de los Estados Unidos, México y América del Sur. La infección ocurre cuando las esporas del hongo son inhaladas. La mayoría de las personas infectadas no presentan síntomas, pero algunas pueden desarrollar una enfermedad pulmonar grave.
Estructura y Morfología de los Hongos Microscópicos
Células y Estructuras de los Hongos Microscópicos
Las células de los hongos microscópicos son eucariotas, lo que significa que tienen un núcleo que contiene su ADN. También tienen una variedad de orgánulos, incluyendo mitocondrias para la producción de energía, retículo endoplasmático para la síntesis de proteínas y lípidos, y aparato de Golgi para la modificación y el transporte de proteínas.
Además de estos orgánulos comunes, las células de los hongos microscópicos también tienen algunas características únicas. Por ejemplo, tienen paredes celulares hechas de quitina, un polisacárido resistente que también se encuentra en los exoesqueletos de los insectos. Las paredes celulares proporcionan estructura y protección a las células del hongo.
Los hongos microscópicos también pueden formar estructuras multicelulares complejas. Por ejemplo, los hongos filamentosos crecen en forma de hifas, que son largos filamentos de células. Las hifas pueden entrelazarse para formar una red llamada micelio. El micelio es la estructura de crecimiento principal de muchos hongos, y puede penetrar en el suelo o en los substratos orgánicos para obtener nutrientes.
Reproducción y Ciclo de Vida de los Hongos Microscópicos
Los hongos microscópicos pueden reproducirse tanto sexual como asexualmente. La reproducción asexual ocurre cuando una célula de hongo se divide para producir dos células hijas, o cuando un hongo produce esporas asexuales que pueden dispersarse y crecer en nuevos organismos. La reproducción asexual permite a los hongos proliferar rápidamente y colonizar nuevos ambientes.
La reproducción sexual en los hongos microscópicos es más compleja y puede implicar la fusión de células o hifas de diferentes individuos. La reproducción sexual produce esporas sexuales que tienen una combinación única de genes de ambos padres. Estas esporas pueden dispersarse y crecer en nuevos hongos que tienen una diversidad genética mayor que la de sus padres. Esta diversidad genética puede ayudar a los hongos a adaptarse a nuevos ambientes o a resistir enfermedades y parásitos.
Métodos de Identificación de Hongos Microscópicos
Examen Microscópico
El método más común para identificar hongos microscópicos es a través del examen microscópico. Los hongos se recolectan de su ambiente natural, se colocan en un portaobjetos y se examinan bajo un microscopio. Los científicos buscan características específicas, como la forma y el tamaño de las esporas, la presencia de ciertas estructuras celulares y la forma en que las células del hongo se dividen y crecen.
Pruebas Bioquímicas y Moleculares
Además del examen microscópico, los científicos también pueden utilizar pruebas bioquímicas y moleculares para identificar hongos microscópicos. Las pruebas bioquímicas pueden incluir la exposición del hongo a diferentes sustancias químicas y la observación de cómo reacciona. Las pruebas moleculares, por otro lado, implican el análisis del ADN del hongo. Al comparar la secuencia de ADN del hongo con las secuencias de ADN en una base de datos, los científicos pueden determinar la especie del hongo.
Importancia de la Identificación de Hongos Microscópicos
Salud Humana
La identificación precisa de los hongos microscópicos es crucial para la salud humana. Algunos hongos microscópicos pueden causar enfermedades en los humanos, especialmente en aquellos con sistemas inmunológicos debilitados. Al identificar correctamente el hongo causante de la enfermedad, los médicos pueden prescribir el tratamiento más efectivo.
Investigación Científica
La identificación de hongos microscópicos también es esencial para la investigación científica. Los hongos microscópicos son un componente importante de muchos ecosistemas y su identificación puede ayudar a los científicos a entender mejor estos ecosistemas. Además, los hongos microscópicos pueden ser utilizados en la investigación de laboratorio para estudiar una variedad de procesos biológicos.
Desafíos en la Identificación de Hongos Microscópicos
A pesar de los avances en la tecnología y las técnicas de identificación, la identificación de hongos microscópicos sigue siendo un desafío. Los hongos microscópicos son increíblemente diversos, con miles de especies aún por descubrir. Además, muchos hongos microscópicos pueden tener una apariencia similar bajo el microscopio, lo que dificulta su identificación.
Hongos Microscópicos y Salud Humana
Enfermedades Causadas por Hongos Microscópicos
Los hongos microscópicos pueden causar una variedad de enfermedades en los humanos. Algunas de estas enfermedades son relativamente menores, como las infecciones por hongos en la piel o las uñas. Sin embargo, otros hongos microscópicos pueden causar enfermedades graves, especialmente en personas con sistemas inmunológicos debilitados.
Por ejemplo, el hongo Candida puede causar infecciones oportunistas en personas con sistemas inmunológicos debilitados. Estas infecciones pueden variar desde la candidiasis oral y vaginal hasta infecciones sistémicas potencialmente mortales. Otro hongo, Aspergillus, puede causar aspergilosis, una infección pulmonar que puede ser grave en personas con enfermedades pulmonares preexistentes o sistemas inmunológicos debilitados.
Además, algunos hongos microscópicos pueden causar enfermedades sistémicas graves incluso en personas con sistemas inmunológicos saludables. Por ejemplo, el hongo Histoplasma puede causar histoplasmosis, una enfermedad que puede variar desde una enfermedad leve similar a la gripe hasta una enfermedad pulmonar grave. Otro hongo, Coccidioides, puede causar coccidioidomicosis, o fiebre del valle, una enfermedad que puede causar síntomas que van desde fatiga y fiebre hasta erupciones cutáneas y problemas respiratorios graves.
Prevención y Tratamiento de Infecciones por Hongos Microscópicos
La prevención de las infecciones por hongos microscópicos a menudo implica evitar la exposición a los hongos. Por ejemplo, las personas que viven en áreas donde la histoplasmosis o la coccidioidomicosis son comunes pueden evitar actividades que remuevan el suelo y liberen esporas de hongos al aire. Las personas con sistemas inmunológicos debilitados pueden necesitar tomar precauciones adicionales, como evitar áreas con moho o usar máscaras cuando están al aire libre.
El tratamiento de las infecciones por hongos microscópicos depende de la gravedad de la infección. Las infecciones menores de la piel o las uñas a menudo pueden ser tratadas con medicamentos antifúngicos tópicos. Las infecciones más graves, como la aspergilosis o la candidiasis sistémica, pueden requerir medicamentos antifúngicos orales o intravenosos. En algunos casos, puede ser necesario el tratamiento a largo plazo para prevenir la recurrencia de la infección.
Hongos Microscópicos en la Industria y la Ciencia
Uso de Hongos Microscópicos en la Producción de Alimentos y Bebidas
Los hongos microscópicos tienen una larga historia de uso en la producción de alimentos y bebidas. Por ejemplo, la levadura Saccharomyces cerevisiae ha sido utilizada durante miles de años para fermentar el pan, la cerveza y el vino. Durante la fermentación, la levadura descompone los azúcares y produce alcohol y dióxido de carbono. El alcohol es lo que da a la cerveza y al vino su contenido alcohólico, mientras que el dióxido de carbono es lo que hace que el pan suba.
Otros hongos microscópicos también se utilizan en la producción de alimentos. Por ejemplo, el hongo Aspergillus oryzae se utiliza en la producción de alimentos fermentados como el sake, la salsa de soja y el miso. Este hongo produce enzimas que descomponen los almidones y las proteínas en estos alimentos, dando lugar a sabores y texturas únicos.
Hongos Microscópicos en la Investigación Científica
Los hongos microscópicos también son herramientas valiosas en la investigación científica. Por ejemplo, la levadura Saccharomyces cerevisiae es un organismo modelo popular en la biología celular y molecular. Los científicos han utilizado S. cerevisiae para estudiar una variedad de procesos biológicos, desde el ciclo celular hasta la señalización celular y la genética.
Además, los hongos microscópicos son útiles en la investigación de enfermedades humanas. Por ejemplo, los científicos pueden estudiar las infecciones por hongos en modelos animales o en cultivos celulares para aprender más sobre cómo los hongos causan enfermedades y cómo el sistema inmunológico responde a estas infecciones. Este tipo de investigación puede ayudar a desarrollar nuevos tratamientos para las infecciones por hongos.
Conservación y Diversidad de los Hongos Microscópicos
Amenazas a la Diversidad de Hongos Microscópicos
A pesar de su importancia en los ecosistemas y en la industria, los hongos microscópicos enfrentan una serie de amenazas. La pérdida de hábitat, la contaminación y el cambio climático pueden todos tener un impacto en la diversidad y la abundancia de los hongos microscópicos.
Por ejemplo, la deforestación y el desarrollo pueden destruir los hábitats de los hongos microscópicos, lo que puede llevar a la pérdida de especies. La contaminación, como los pesticidas y los metales pesados, puede dañar a los hongos microscópicos y alterar las comunidades de hongos. El cambio climático también puede tener un impacto, ya que las temperaturas más cálidas y los cambios en los patrones de precipitación pueden alterar los hábitats de los hongos y afectar su capacidad para sobrevivir y reproducirse.
Esfuerzos de Conservación para los Hongos Microscópicos
A pesar de estas amenazas, hay esfuerzos en curso para conservar los hongos microscópicos. Estos esfuerzos incluyen la investigación para entender mejor la diversidad y la ecología de los hongos microscópicos, así como las acciones para proteger y restaurar los hábitats de los hongos.
Por ejemplo, los científicos están utilizando técnicas de secuenciación de ADN para identificar y catalogar las especies de hongos microscópicos. Este tipo de investigación puede ayudar a identificar las especies que están en peligro y a entender mejor cómo los hongos microscópicos interactúan con otros organismos y su entorno.
Además, los esfuerzos de conservación pueden incluir la protección de los hábitats de los hongos, como los bosques y los suelos, y la restauración de los hábitats que han sido dañados o degradados. Estas acciones pueden ayudar a preservar la diversidad de los hongos microscópicos y a mantener los importantes roles que desempeñan en los ecosistemas.
Conclusiones y Perspectivas Futuras
Avances Recientes en la Investigación de Hongos Microscópicos
La investigación sobre los hongos microscópicos ha avanzado rápidamente en los últimos años. Los avances en la tecnología de secuenciación de ADN han permitido a los científicos identificar y catalogar miles de especies de hongos microscópicos. Además, los estudios de laboratorio y de campo han proporcionado nuevos conocimientos sobre la biología y la ecología de los hongos microscópicos.
Por ejemplo, los científicos han descubierto que los hongos microscópicos juegan un papel crucial en los ciclos de nutrientes en los ecosistemas terrestres. Los hongos descomponen la materia orgánica y liberan nutrientes que pueden ser utilizados por las plantas y otros organismos. Además, los hongos forman relaciones simbióticas con las plantas, ayudándolas a absorber agua y nutrientes del suelo.
El Futuro de la Investigación y Aplicación de los Hongos Microscópicos
A medida que avanzamos en el siglo XXI, es probable que los hongos microscópicos sigan desempeñando un papel importante en la ciencia y la industria. Por ejemplo, los hongos microscópicos pueden tener aplicaciones en la producción de alimentos y bebidas, la biotecnología y la medicina.
Además, a medida que enfrentamos desafíos globales como el cambio climático y la pérdida de biodiversidad, los hongos microscópicos pueden desempeñar un papel crucial en la mitigación de estos problemas. Por ejemplo, los hongos pueden ayudar a descomponer los desechos orgánicos y reciclar los nutrientes, lo que puede ayudar a mantener la salud de los ecosistemas y reducir la necesidad de fertilizantes sintéticos.
Los hongos microscópicos son un grupo de organismos fascinantes y vitales. Aunque son pequeños, su impacto en el mundo es inmenso. A través de la investigación y la conservación, podemos trabajar para entender mejor a estos organismos y asegurar que sigan desempeñando su papel crucial en el mundo.
Referencias:
- Pineda Sopo, C. J., Hajati, F., & Gheisari, S. (2021). DeFungi: Direct Mycological Examination of Microscopic Fungi Images. Recuperado de http://arxiv.org/abs/2109.07322v1
- Yilmaz, A., Goktay, F., Varol, R., Gencoglan, G., & Uvet, H. (2021). Deep Convolutional Neural Networks for Onychomycosis Detection. Recuperado de http://arxiv.org/abs/2106.16139v3
- Zielinski, B., Sroka-Oleksiak, A., Rymarczyk, D., Piekarczyk, A., & Brzychczy-Wloch, M. (2019). Deep learning approach to description and classification of fungi microscopic images. Recuperado de http://arxiv.org/abs/1906.09449v3
- Gómez Brandón, M., & Domínguez, J. (2021). Hongos en el proceso de vermicompostaje. En Vermicompostaje. Springer, Cham. Recuperado de https://link.springer.com/chapter/10.1007/978-3-030-10453-9_7
- Gómez Brandón, M., Lores, M., & Domínguez, J. (2010). Species-dependent influence of earthworms on microbial communities during vermicomposting. Pedobiologia, 53(5), 283-294. Recuperado de https://www.sciencedirect.com/science/article/pii/S0031405610000546
- Gondek, K., & Filipek-Mazur, B. (2003). Biomass yields of shoots and roots of plants cultivated in soil amended by vermicomposts based on tannery sludge and content of heavy metals in plant tissues. Plant, Soil and Environment, 49(9), 402-409. Recuperado de https://www.researchgate.net/publication/228476670_Biomass_yields_of_shoots_and_roots_of_plants_cultivated_in_soil_amended_by_vermicomposts_based_on_tannery_sludge_and_content_of_heavy_metals_in_plant_tissues
- Zielinski, B., Sroka-Oleksiak, A., Rymarczyk, D., Piekarczyk, A., & Brzychczy-Wloch, M. (2020). Deep learning approach to describe and classify fungi microscopic images. Recuperado de http://arxiv.org/abs/2005.11772v1
- Bezzi, M., & Ciliberto, A. (2004). Mathematical modeling of filamentous microorganisms. Recuperado de http://arxiv.org/abs/q-bio/0402004v1

